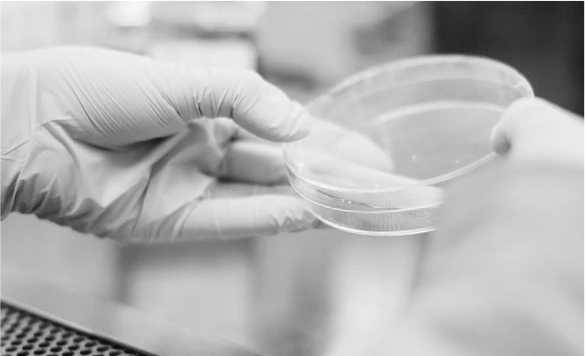

Interventions et médecine esthétique
Prise en charge de la transition pour personnes transgenres
Nombreux sont les patients en transition qui souhaitent bénéficier d’une chirurgie de réassignation du genre, que cela concerne les organes génitaux, ou les caractères sexuels secondaires tels que la poitrine, ou la face.
Spécialiste en chirurgie de réassignation dans le sens Femme-vers-Homme (FtM) ou Homme-vers-Femme (MtF), le Professeur David Boccara est entouré d’une équipe médicale et paramédicale qui vous accompagnera tout au long de votre démarche. Une prise en charge multi-disciplinaire est un pré-requis indispensable au bon déroulement des interventions et des suites opératoires.
L’Hôpital Saint Louis est depuis de nombreuses années une référence en matière de transidentité.
HOPITAL SAINT LOUIS
Le Professeur David Boccara exerce exclusivement à l’Hôpital Saint Louis à Paris, Centre de Référence en Chirurgie Plastique Plastique Reconstructrice et Esthétique.
Constitué de 2 unités conventionnelles d’hospitalisation, d’une unité de Chirurgie Ambulatoire, du Centre Régional de prise en charge des patients Brûlés, le service de Chirurgie Plastique possède les équipements les plus modernes et innovants.
Equipé d’un plateau chirurgical à la pointe de la technologie, de deux réanimations et d’équipes médicale et paramédicale expérimentées, la prise en charge pré, per et post-opératoire est personnalisée et sécurisée.
1 Avenue Claude Vellefaux, 75010 Paris
secretariatprboccara@hotmail.com
06. 50. 86. 02. 29
RECHERCHES ET PUBLICATIONS
Le Professeur David Boccara est responsable d’enseignement à la Faculté de Paris.
Responsable du Diplôme Universitaire de « Plaies et cicatrisations » et « d’anatomie des lambeaux en Chirurgie Plastique », le Professeur Boccara assure également l’enseignement du DESC de Chirurgie Plastique Plastique Reconstructrice et Esthétique, et du Diplôme Universitaire « de Brûlures ».
Auteur d’une Thèse de Sciences Fondamentales sur ces Thématiques, le Professeur David Boccara est titulaire d’une Habilitation à Diriger le Recherche (HDR). Il encadre les travaux de Recherche Clinique et Scientifiques en Chirurgie Plastique Reconstructrice et Esthétique, Traitement des Brûlures, et Prise en Charge des Patients Transidentitaires.

Chercheur Associé au sein de l’équipe 2 de recherche « Immuno-Inflammation Cutanée » (INSERM U 976) du Centre de Recherche Saint Louis de l’Université de Paris, et au sein du CIMI-PARIS. (INSERM U 1135) de l’Univeriste Paris 6 La Sorbonne, le Professeur David Boccara travaille principalement sur le Vieillissement, la Cicatrisation, et l’Immunité de la peau.
Ces travaux ont donné lieu à plus de 80 publications dans des revues internationales. Le Professeur David Boccara a ainsi mis au point de nombreuses techniques innovantes en Chirurgie Esthétique.
Auteur d’une thèse sur l’évaluation photographique des Brûlures, il a développé la Télémedecine en Chirurgie Plastique, ce qui permet un suivi et une prise en charge 24h/24 des suites opératoires.